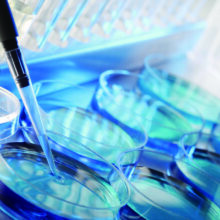

感谢您一直以来对 5Star Medical Club 和 CLINIC 9ru 的支持与厚爱。
近期,我们收到部分中国客户的询问,因“CLINIC 9ru”这一名称在中文发音上与某些词汇相似,是否为中国资本背景的诊所。
在此郑重说明:CLINIC 9ru 是由100%日本人资本出资设立的医疗法人机构,属于日本国内的正规医疗机构。其经营与运营完全在日本国内完成,与任何海外资本或外国投资者均无关联。
此外,本院的医疗团队全部由日本国内持有正规资格的医生与医护人员组成,确保提供高水平的专业医疗服务。
“CLINIC 9ru”这一名称来源于日语及日本文化背景,并无任何外语含义,也并非为了营造外资企业的印象。
5Star Medical Club 与 CLINIC 9ru 将一如既往地在“安心・安全”的前提下,持续提供融合日本先进医疗与高品质服务的医疗体验。感谢您的支持与信赖,敬请继续关注。